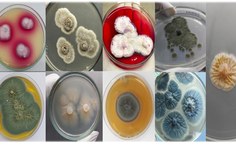
Alysson Duarte tem pesquisado os micro-organismos da Antártica desde a época do doutorado na USP com as leveduras do polo Sul para produção de enzimas lipases

Livro com pesquisas da Ufal une a microbiologia polar à ciência climática
A obra publicada pela editora internacional Springer contou com a edição e organização de um professor da Ufal no Campus Arapiraca

O livro Polar Microbes and Climate Change: A Molecular Understanding for Sustainable Future, de tradução livre Micróbios polares e mudanças climáticas: uma compreensão molecular para um futuro sustentável, aborda a diversidade e as estratégias moleculares de micro-organismos que vivem em ambientes polares. A obra editada pelo professor da Ufal Campus Arapiraca, Alysson Duarte, destaca como eles se adaptam aos diferentes limites ambientais como o frio intenso, o excesso de radiação UV, a desidratação e escassez de nutrientes.
Nas pesquisas apresentadas, Duarte também mostra como esses micro-organismos são importantes para os ciclos de carbono e nitrogênio, podendo oferecer soluções biotecnológicas para mitigar as mudanças climáticas, focando em um futuro mais sustentável através da compreensão de sua genética e adaptação. Um dos temas emergentes que foi abordado no livro foi o impacto dos microplásticos nas comunidades microbianas dos ambientes polares.
A obra foi organizada em colaboração com outros pesquisadores editores, como o brasileiro Michel Passarini (Universidade Federal da Integração Latino-Americana), Josef Elster (University of South Bohemia, República Tcheca), Ajay Kumar (Amity University. Índia) e Prashant Kumar Singh (Pacchunga University College, Índia).
São três temáticas principais que o livro apresenta: Diversidade molecular e as adaptações ecofisiológicas dos micro-organismos adaptados ao frio; Mudanças climáticas e comunidade microbiana das regiões polares e; Adaptações moleculares e biotecnologia microbiana. A obra é composta por 14 capítulos e o grupo de pesquisa coordenado pelo professor Alysson liderou a escrita de cinco deles (os capítulos 6, 7, 9, 10 e 13).
Participaram do processo de construção dos capítulos alunos de graduação em Medicina e Ciências Biológicas do Campus Arapiraca, além de alunos de mestrado dos programas Agricultura e Ambiente (PPGAA) e Ciências Médicas, e os doutorandos do Renorbio e PPGEQ. Os professores da Ufal Arapiraca Adeildo Oliveira e Thaíssa Lucio colaboraram junto com os docentes do Campus A.C. Simões, Aline Queiroz e Magna Suzana, além de Luiz Rosa (UFMG), Michel Passarini (Unila), Paulo Camara (UnB), Valéria Maia (Unicamp), e Lara Sette (Unesp).
“O livro é uma obra abrangente que une a microbiologia polar à ciência climática, oferecendo uma perspectiva molecular sobre como a vida está adaptada no frio extremo e como essa compreensão pode ajudar no combater às mudanças climáticas e um futuro mais sustentável”, destacou Duarte.
Alysson Duarte tem pesquisado os micro-organismos da Antártica desde a época do doutorado na USP com as leveduras do polo Sul para produção de enzimas lipases. Esteve em três expedições à Antártica (2013, 2017 e 2022) e atualmente pesquisa os micro-organismos da Antártica para aplicação agrícola, produção de enzimas e metabólitos com ação antimicrobiana, antioxidante e fotoprotetiva. “Buscamos sempre uma aplicação para problemas reais com micro-organismos ainda pouco conhecidos, como os isolados da Antártica”, completou.
As pesquisas são feitas com apoio financeiro da Fapeal, Capes e do CNPq.